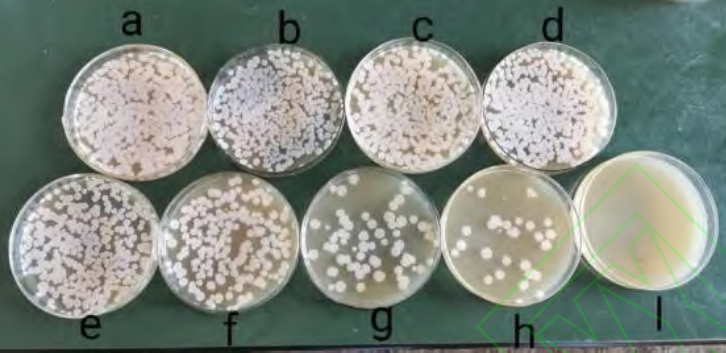

ARTP与5-BU复合诱变及快速选育腺苷高产菌株
来源: 作者:天木生物 发布时间:2020-05-19 11:32 浏览量:214
本期为您推荐安徽工程大学生物与化学工程学院,微生物发酵安徽省工程技术研究中心薛正莲研究团队发表在《食品与发酵工业》上的一篇文章:ARTP与5-BU复合诱变及快速选育腺苷高产菌株。
文章摘要内容如下:
腺苷是一种遍布人体细胞的重要的内源性核苷酸,因其具有非常重要的生化代谢和调节功能而被人们熟知。目前腺苷菌株主要通过诱变选育的方式得到,高效的诱变技术及筛选方法可大大提高获得高产菌株的效率。
本研究采用常温室压等离子体(ARTP)与5-溴尿嘧啶(5-BU)对枯草芽孢杆菌B-0进行复合诱变,通过磺胺胍(SG)抗性初筛、48孔板定量复筛的培养方法快速选育腺苷高产菌株。结果显示,48孔板在枯草芽孢杆菌发酵过程中存在边缘孔效应,并应用2mL无菌水填充可消除边缘孔效应,且通过6轮复合诱变最终获得一株较出发菌株腺苷产量提升35%的遗传稳定的突变株B-6。
由清华大学自主研发的新型常压室温等离子体(ARTP)微生物快速突变技术具有安全性高,操作简单,突变率高等优势。ARTP可快速地突变细菌、真菌等多种微生物,是可以快速高效地获得高产菌株的新型诱变手段。本研究运用ARTP于5-BU相结合的方法是选育高产菌株的有效手段,也为其他产核苷类物质菌株的选育提供了参考。
文章精彩内容如下:
图3 不同SG浓度平板筛选突变株

图7 6轮ARTP诱变复筛结果

图8 突变株B-6产腺苷的遗传稳定性
